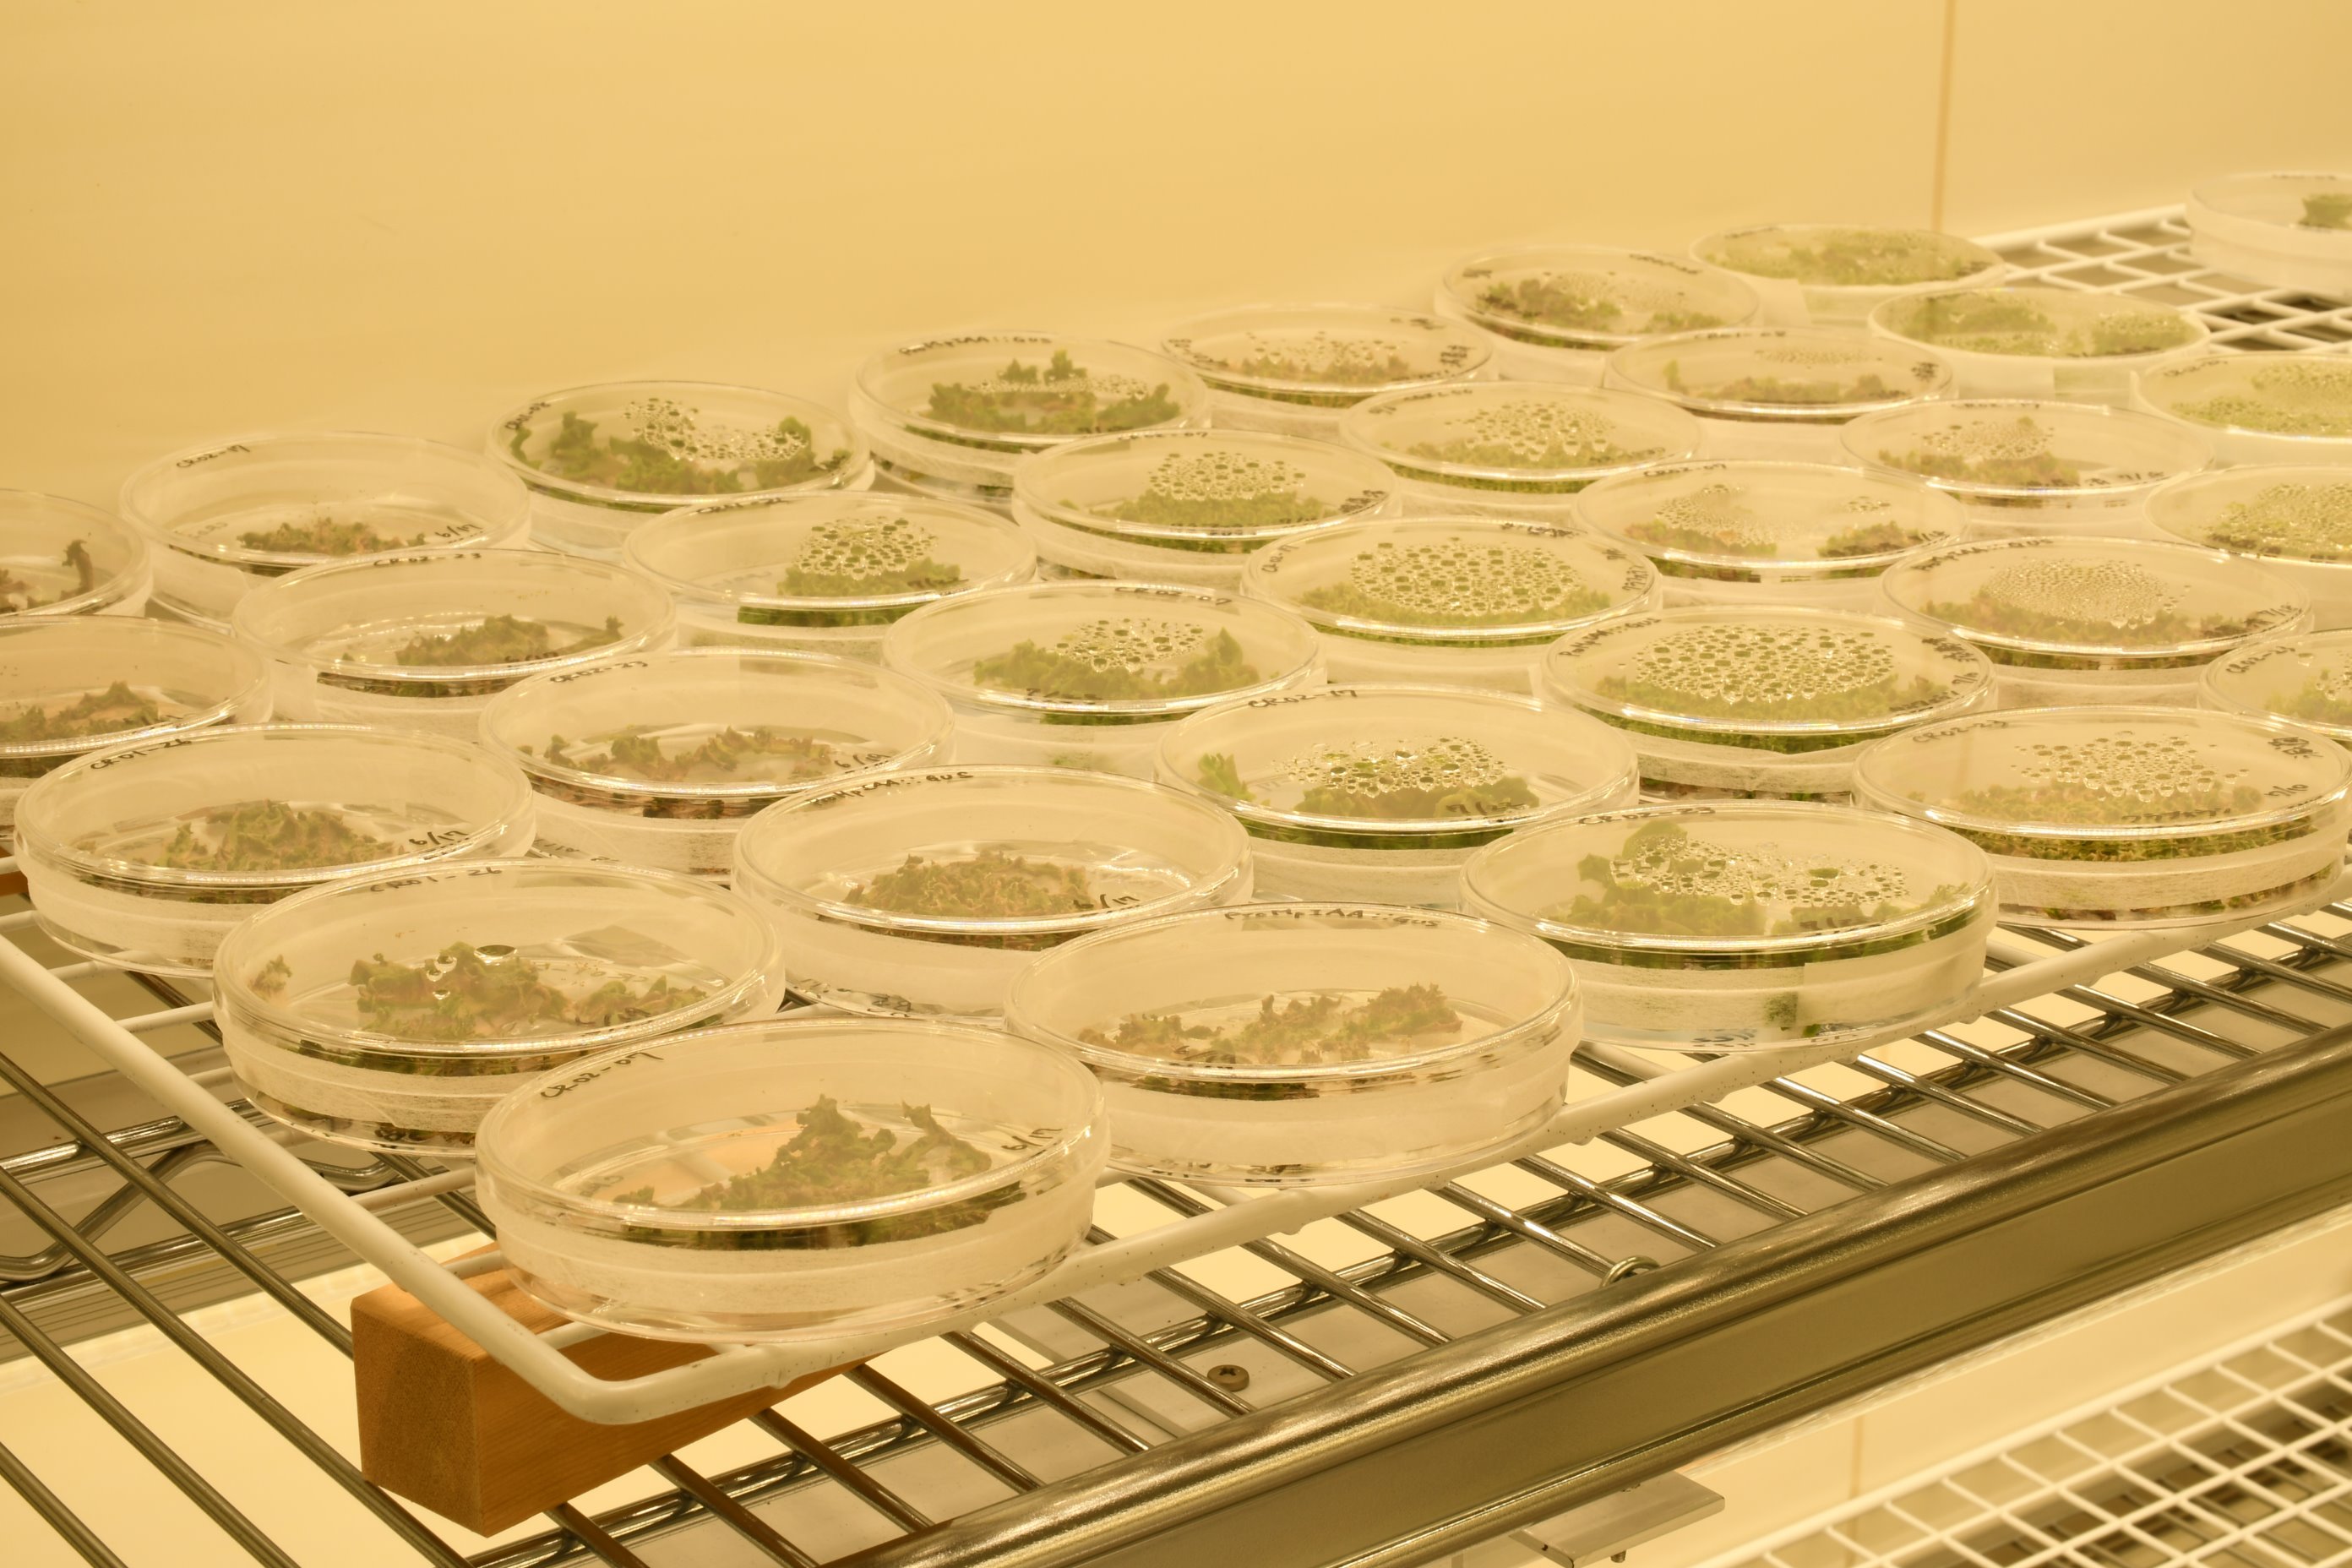
植物によるバイオものづくりプラットフォーム | 環境資源科学研究センター

激安スーパーの“売上対決” 東京理研ページ ハイパーカミオカンデ中間検出器施設の着工式を開催しました - KEK|高 その他
(3083件)
Pontaパス特典
サンキュー配送
42400円(税込)
424ポイント(1%)
Pontaパス会員ならさらに+1%ポイント還元!
送料
(
)
3082
配送情報
お届け予定日:2026.04.16 22:10までにお届け
※一部地域・離島につきましては、表示のお届け予定日期間内にお届けできない場合があります。
ロットナンバー
870423363
お買い物の前にチェック!

Pontaパス会員なら
ポイント+1%
ポイント+1%
商品説明
商品に興味をもっていただき、ありがとうございます。【商品の説明】ビリヤード球 象牙風 赤×2点.白×2点 計4点直径約6.5cm専用箱 付属します。状態は悪いです。【商品の状態】中古品 長期保管品経年劣化による傷、汚れ等があります。現状でのお渡しとなります。写真にてご確認ください。神経質な方はお控えください。| カテゴリー: | ゲーム・おもちゃ・グッズ>>>おもちゃ>>>その他 |
|---|---|
| 商品の状態: | やや傷や汚れあり","目につく傷や汚れがある |
| 配送料の負担: | 送料込み(出品者負担) |
| 配送の方法: | 佐川急便/日本郵便 |
| 発送元の地域: | 富山県 |
| 発送までの日数: | 1~2日で発送 |
レビュー
商品の評価:




 4.3点(3083件)
4.3点(3083件)
- PP503
- 283123-20141221-0565696101 4ヶ月の息子にクリスマスプレゼントです。 カミカミしたり鏡で自分の顔を見たり喜んでるようにみえます。 ベビーカーに着けてます。 注文してよかったです。
- f64k
- 車好きでハンドルを握りたがって運転に支障が出てたんですが、これが来てからちゃんとベビーシートに座ってくれるようになりました。
- まーめいどさらだ
- 色々な機能があり子供もとても気に入ったらしく使用中はずっと笑ってます!
すべて見る
お店の情報
7,367
連絡・応対
4.3
配送スピード
4.3
梱包
4.3